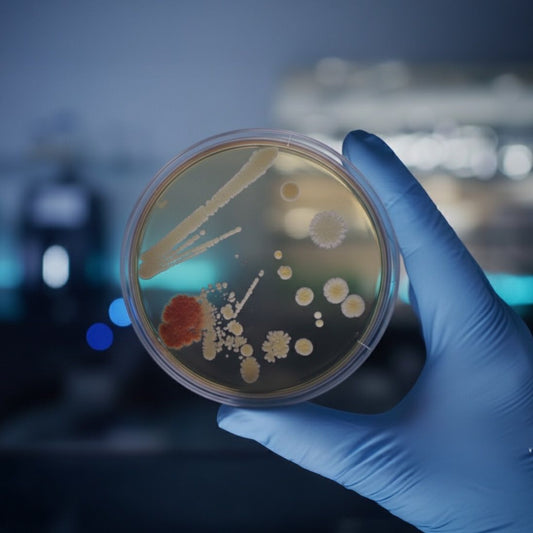
Lactobacillus Ferment Filtrate: The Quiet Power Behind Resilient Skin

Nu Allumé Blog
Nu Allumé Blog
Menopause Wrinkles and Collagen Loss: What Changes
Menopause Wrinkles and Collagen Loss: What Changes and Why
Menopause can influence collagen levels, skin thickness and elasticity. As oestrogen declines during perimenopause, menopause and post-menopause, collagen production can decrease, which may contribute to thinner skin, reduced firmness and more noticeable lines.
If you are searching for menopause wrinkles, collagen loss menopause, thinning skin menopause or loss of elasticity menopause, these are common structural changes linked to hormonal transition.
Does Menopause Cause Collagen Loss?
Yes. Oestrogen supports collagen production. As oestrogen declines, collagen levels can reduce and skin structure can change. This is one reason fine lines and wrinkles may appear more noticeable during menopause.
Why Skin Can Feel Thinner After Menopause
Thinning skin during menopause can be linked to reduced collagen and changes in dermal density. When skin becomes less dense, it may feel more fragile and fine lines may appear more visible, particularly when hydration is low.
For a broader overview of hormonal skin shifts, see our guide to menopause skin changes.
Loss of Elasticity During Menopause
Collagen and elastin fibres support firmness and bounce. As these structural proteins decline, skin may feel less firm and elasticity can reduce over time.
How to Support Menopause Skin Comfort and Visible Resilience
Maintain consistent hydration to support comfort
Choose barrier-supportive moisturisers
Use gentle cleansing to avoid unnecessary stripping
Support daily sun protection
In the evening, a richer moisturiser can support overnight hydration and comfort. Explore our Postbiotic Berry Night Moisturiser.
During the day, consistent hydration can support comfort. Explore our Aloe & Snow Peach Postbiotic Day Moisturiser.
A lightweight serum designed for hormonally changing skin can support overall comfort. Explore our Rosella Radiance Prebiotic Serum.
Frequently Asked Questions
Does menopause accelerate wrinkles?
Declining oestrogen can influence collagen levels, which may contribute to more noticeable lines during menopause.
Why does my skin feel thinner after menopause?
Reduced collagen can decrease dermal density, making skin feel thinner and less resilient.
Can skincare replace collagen lost during menopause?
Skincare supports hydration and barrier comfort, but it does not replace structural proteins.
The Bottom Line
Menopause wrinkles and thinning skin are common changes linked to collagen decline and structural shifts during hormonal transition. A consistent, barrier-supportive routine helps maintain comfort and visible resilience.
Menopause Itchy Skin: Causes of Sensitivity Explained
Menopause Itchy Skin and Sensitivity: Why It Happens
Menopause itchy skin and increased sensitivity are common during perimenopause, menopause and post-menopause. As oestrogen declines, hydration can decrease and the skin barrier can become more vulnerable, which may make skin feel itchy, reactive or unusually sensitive.
If you are searching for menopause itchy skin, why does menopause make skin itchy, or menopause sensitive skin, this is often linked to dryness and barrier change rather than a sudden need for stronger products.
Why Does Menopause Make Skin Itchy?
Oestrogen supports hydration, collagen levels and barrier strength. As levels decline, natural lipids can decrease and water loss can increase. When skin becomes drier and more fragile, itching can occur even without a visible rash.
Why Skin Becomes More Sensitive in Perimenopause
Perimenopause sensitive skin is often linked to barrier vulnerability. When the barrier is less resilient, environmental triggers can affect the skin more easily and products that once felt fine may begin to sting or feel uncomfortable.
For a broader explanation of hormonal skin shifts, see our guide to menopause skin changes.
How to Support Menopause Itchy and Sensitive Skin
Choose gentle cleansing to avoid stripping natural lipids
Maintain consistent hydration to support barrier comfort
Reduce over-exfoliation
Limit heavily fragranced or overly aggressive routines
A gentle cleansing crème can help reduce unnecessary irritation. Explore our Postbiotic Papaya Cleansing Crème.
Daily moisturisation designed for hormonally changing skin can support comfort. Explore our Aloe & Snow Peach Postbiotic Day Moisturiser.
In the evening, a richer moisturiser can support overnight comfort. Explore our Postbiotic Berry Night Moisturiser.
Frequently Asked Questions
Why is my skin itchy during menopause even without a rash?
Declining oestrogen can reduce hydration and weaken barrier function, which can increase dryness and contribute to itch sensation.
Can perimenopause cause sensitive skin?
Yes. Hormonal fluctuations during perimenopause can affect hydration and barrier resilience, which may increase reactivity.
Does menopause itching go away?
Some sensitivity stabilises, but dryness-related itch can persist without consistent barrier support.
The Bottom Line
Menopause itchy skin and increased sensitivity are common changes linked to hydration loss and barrier vulnerability during hormonal transition. A gentle, supportive routine can help maintain comfort.
Menopause Skincare Routine: Perimenopause to Post-Menopause
Menopause Skincare Routine by Stage: Perimenopause, Menopause and Post-Menopause
A menopause skincare routine should adapt to hormonal stage, skin behaviour and barrier resilience. As oestrogen declines, hydration, collagen production and oil balance can shift, meaning skin often benefits from a gentler, more supportive approach.
If you are searching for menopause skincare routine, best skincare for menopause skin, perimenopause skincare routine or post-menopause skincare routine, this guide outlines how to approach skincare during each stage of hormonal transition.
Why Menopause Requires a Different Skincare Routine
During perimenopause, menopause and post-menopause, skin commonly experiences reduced oil production, increased dryness, barrier vulnerability, changes in elasticity, occasional breakouts and increased sensitivity.
Many women find traditional anti-ageing routines can feel too harsh during this stage. A menopause skincare routine often focuses on barrier support, hydration consistency and gentle cleansing.
For a complete overview of hormonal skin changes, explore our guide to menopause skin changes.
Perimenopause Skincare Routine
Perimenopause skin changes often begin gradually. Hormones fluctuate rather than decline consistently, which means skin may feel inconsistent.
Common perimenopause concerns include occasional dryness, increased sensitivity, hormonal acne and subtle loss of elasticity.
Morning Routine for Perimenopause
Gentle cleansing to support comfort and avoid stripping natural lipids. Explore our Postbiotic Papaya Cleansing Crème.
Lightweight serum designed for hormonally transitioning skin. Explore our Rosella Radiance Prebiotic Serum.
Barrier-supportive moisturiser for daily hydration and comfort. Explore our Aloe & Snow Peach Postbiotic Day Moisturiser.
Broad-spectrum sunscreen for daily protection.
Menopause Skincare Routine
During menopause, oestrogen decline becomes more pronounced. Structural and hydration changes may accelerate, contributing to persistent dryness, itchy or reactive skin and visible changes in firmness.
Morning Routine for Menopause
Gentle cleansing to avoid stripping natural lipids
Lightweight antioxidant serum for daily environmental support
Barrier-supportive day moisturiser
Daily sun protection
Evening Routine for Menopause
Gentle cleanse
Targeted serum if tolerated
Richer moisturiser for overnight hydration and comfort. Explore our Postbiotic Berry Night Moisturiser.
Post-Menopause Skincare Routine
Post-menopause skin often stabilises hormonally but may remain dry and thinner. Ongoing dryness, reduced oil production and visible lines are common concerns.
Post-menopause skincare typically prioritises consistent hydration, barrier reinforcement, gentle cleansing and avoiding over-exfoliation.
Explore deeper guides based on your main concern:
Dry skin during menopause
Hormonal acne in perimenopause and menopause
Menopause itchy skin and sensitivity
Collagen loss and thinning skin in menopause
The Core Principles of a Menopause Skincare Routine
Regardless of stage, an effective menopause skincare routine typically focuses on:
Respecting the skin barrier
Avoiding unnecessary antibacterial disruption
Maintaining hydration consistency
Supporting skin comfort and visible resilience
Adapting to changing tolerance
Frequently Asked Questions About Menopause Skincare
What is the best skincare routine for menopause?
The best menopause skincare routine typically includes gentle cleansing, barrier-supportive moisturisation, antioxidant support and daily sun protection.
Should I change my skincare during perimenopause?
Many women find skin becomes more sensitive during perimenopause, which can make gentler, more supportive formulations feel more comfortable.
Does post-menopause skin need different products?
Post-menopause skin often benefits from consistent hydration and barrier reinforcement due to ongoing lipid decline.
Can I still use anti-ageing products during menopause?
Yes, but overly aggressive or highly stripping routines may increase irritation. A balanced, barrier-supportive approach is often better tolerated.
The Bottom Line
A menopause skincare routine is not about reversing ageing. It is about supporting hormonally transitioning skin with consistency and barrier-focused care. Understanding the stage-by-stage shifts helps you adjust your routine with confidence.
For the full overview, explore our guide to menopause skin changes.
Hormonal Acne in Menopause: Why Breakouts Return
Hormonal Acne in Menopause: Why Breakouts Can Return
Hormonal acne during menopause can appear unexpectedly, even after years of clear skin. As oestrogen levels decline during perimenopause and menopause, the relative influence of androgens can increase, which may stimulate oil activity and contribute to breakouts.
If you are searching for hormonal acne menopause, acne after menopause, or perimenopause acne, these breakouts are often linked to hormonal transition rather than teenage-style acne.
Can Menopause Cause Acne?
Yes. As oestrogen declines, the balance between oestrogen and androgens shifts. Even if androgen levels do not dramatically rise, their relative influence can become more noticeable. This may increase oil production and contribute to clogged pores and inflammatory breakouts.
Hormonal acne during menopause often appears along the lower face, including the jawline and chin.
Why Acne Feels Different During Menopause
Menopause acne can appear alongside dryness and sensitivity. Many women experience the dry yet breaking out paradox, where skin feels dehydrated but still develops blemishes.
For a broader overview of hormonal skin shifts, see our guide to menopause skin changes.
Perimenopause Acne vs Post-Menopause Acne
Perimenopause acne may fluctuate as hormones rise and fall. Post-menopause acne can feel less cyclical but may persist in some women due to ongoing androgen influence and structural skin changes.
How to Support Hormonal Acne During Menopause
Avoid harsh, stripping cleansers
Maintain hydration to support the skin barrier
Limit over-exfoliation
Choose formulations designed for hormonally changing skin
A lightweight serum designed for hormonally transitioning skin can support comfort. Explore our Rosella Radiance Prebiotic Serum.
Gentle cleansing can help maintain balance. Explore our Postbiotic Papaya Cleansing Crème.
Frequently Asked Questions
Why am I getting acne during menopause?
Shifting hormone balance, including the relative influence of androgens, can stimulate oil activity and contribute to breakouts.
Is menopause acne permanent?
For some women, breakouts stabilise over time. Others may experience occasional acne post-menopause.
Where does hormonal acne appear during menopause?
It often appears along the jawline, chin and lower face.
The Bottom Line
Hormonal acne during menopause is biologically driven and often reflects changing hormone balance. Supporting the skin barrier while avoiding overly aggressive routines can help maintain comfort.
Menopause Skin Changes: Dryness, Acne and Sensitivity
Menopause Skin Changes: Why Skin Becomes Dry, Sensitive, Acne-Prone and Thinner
Menopause skin changes are driven by hormonal shifts that can affect collagen, oil production, hydration levels and barrier function. As oestrogen declines during perimenopause, menopause and post-menopause, skin often becomes drier, more sensitive, less elastic and sometimes prone to breakouts.
If you are searching for menopause skin changes, dry skin menopause, menopause itchy skin, hormonal acne menopause, menopause wrinkles, or perimenopause skin changes, you are not imagining it. These changes are biologically real.
This guide explains what causes menopause skin changes, why they happen and how to support your skin during this transition.
What Are Menopause Skin Changes?
Menopause skin changes refer to visible and functional shifts in the skin associated with declining oestrogen levels.
Common menopause skin symptoms include:
Persistent dryness
Itchy or reactive skin
Increased sensitivity
Hormonal acne
Redness or flushing
Thinning skin
Loss of elasticity
Fine lines becoming more noticeable
These changes often begin during perimenopause, sometimes years before periods stop completely.
Why Does Menopause Cause Dry Skin?
Dry skin during menopause is linked to declining oestrogen, which can reduce lipid production and weaken the skin barrier. When lipid levels decrease, water can escape more easily, leaving skin feeling tight, flaky and persistently dry.
For a deeper explanation, read our guide to dry skin during menopause.
Menopause Itchy Skin and Increased Sensitivity
Menopause itchy skin and increased sensitivity are often linked to hydration loss and barrier vulnerability. When the barrier is less resilient, skin can feel reactive and previously tolerated products may sting.
For a deeper explanation, read our guide to menopause itchy skin and sensitivity.
Hormonal Acne After Menopause
Hormonal acne during menopause can be linked to shifting hormone balance, including the relative influence of androgens as oestrogen declines. This can increase oil activity and contribute to breakouts, often along the jawline and chin.
For a deeper explanation, read our guide to hormonal acne in perimenopause and menopause.
Loss of Elasticity, Wrinkles and Thinning Skin
Declining oestrogen can influence collagen levels and skin structure, which can contribute to thinning skin and more noticeable lines. Supporting hydration and barrier comfort becomes increasingly important during this stage.
For a deeper explanation, read our guide to collagen loss and thinning skin in menopause.
How Perimenopause Skin Changes Differ from Post-Menopause
Perimenopause skin changes can begin gradually and fluctuate. Post-menopause skin may feel more consistently dry, with ongoing concerns around thinning and reduced oil production. Both stages benefit from gentle cleansing, barrier-supportive moisturisation and consistent sun protection.
Does Menopause Affect the Skin Microbiome?
Emerging research suggests hormonal shifts may influence the skin microbiome, the community of microorganisms that supports barrier function and overall skin health. Changes in hydration, oil production and skin pH may influence how this ecosystem behaves. While research continues to evolve, supporting the skin barrier and overall skin environment remains a practical approach.
Best Skincare Routine for Menopause Skin
If you are searching for the best skincare for menopause skin or a menopause skincare routine, consider focusing on:
Gentle cleansing that does not strip natural lipids
Hydration that supports barrier function
Antioxidant support for environmental stress
Evening nourishment for overnight comfort
Consistent broad-spectrum sun protection
For a stage-by-stage guide, explore our menopause skincare routine by stage.
Frequently Asked Questions About Menopause Skin Changes
Why does menopause make skin dry?
Declining oestrogen can reduce lipid production and weaken the skin barrier, increasing water loss and contributing to dryness.
Can menopause cause acne?
Hormonal shifts during perimenopause and menopause can increase oil activity in some women, contributing to breakouts.
Does perimenopause make skin sensitive?
Many women experience increased reactivity during perimenopause due to hydration loss and reduced barrier resilience.
How long do menopause skin changes last?
Some changes begin during perimenopause and stabilise post-menopause, although dryness and thinning may remain ongoing concerns.
The Bottom Line
Menopause skin changes are common and biologically driven. Dryness, sensitivity, breakouts and structural changes reflect hormonal transition. Understanding what is happening helps you choose skincare that supports comfort, hydration and resilience during this stage.
The Missing Badge in Beauty: Healthy Skin
We’ve learned to read the fine print on our food labels. We talk about gut health, probiotics, preservatives, and ingredients that support our bodies. Yet when it comes to our skin, the body’s largest organ, we rarely ask the same questions.
In beauty, the conversation has long revolved around results: smoother, firmer, younger-looking. But skin isn’t a surface to be polished. It’s a living ecosystem, one that changes with age, hormones, environment, and time. True skin health comes from supporting that ecosystem, not fighting it.
At Nu Allumé, every formulation begins with a single principle, skin health first. Before texture, scent, or even performance, we look at how every ingredient interacts with the skin’s microbiome, the invisible community of microbes that protect, repair, and communicate with your skin.
This means thinking differently about how products are built. Moisturisers aren’t just made to hydrate; they’re made to strengthen and support your skin’s natural processes. Cleansers aren’t designed to strip; they’re made to remove impurities without disrupting the skin’s microbiome. Even preservatives are reimagined, not as harsh chemicals that kill everything in sight, but as multifunctional actives that help retain moisture and respect the skin’s delicate environment.
Each decision in formulation is about supporting change, not resisting it, because your skin doesn’t stay the same, and that’s something to honour, not hide. From perimenopause through post-menopause, hormonal shifts alter the skin’s structure and microbiome balance. Our science-led approach meets that reality with understanding, giving skin what it needs to stay comfortable, calm, and resilient through every stage.
We’ve celebrated “clean,” “vegan,” and “cruelty-free.” These are important. But there’s a new topic of choice missing from beauty, the one that says “Healthy Skin”.
So next time you look at the products on your shelf, ask yourself: Is this supporting my skin’s health, or just chasing a result?
Because when we choose to support the skin we live in, not fight against it, that’s where true beauty begins, not in perfection, but in health.
Skin Purging Explained: Why Breakouts Can Happen When Starting Menopause Skincare
Starting a new skincare routine during menopause can be both exciting and frustrating. Many women expect immediate improvements in hydration, texture, and comfort. Instead, some notice new breakouts after only a few days. This temporary reaction is often described as skin purging and it may simply mean that your skin is adjusting to active, science-led formulas.
What Is Skin Purging?
Skin purging occurs when skincare ingredients that encourage renewal, such as fruit acids, postbiotic ferments, or retinol alternatives like bakuchiol, accelerate the skin’s natural cycle of shedding and renewal. Congestion that was already forming beneath the surface is brought forward more quickly, showing up as small pimples, bumps, or whiteheads.
Unlike a regular breakout, which can be triggered by excess oil, hormones, or irritation, purging is linked to the normal renewal process. For many women, it is a short-lived phase on the path to clearer, healthier-looking skin.
Why It Matters for Menopausal Skin
During perimenopause and menopause, the skin naturally becomes thinner, drier, and more reactive. Supporting the skin microbiome with prebiotics and postbiotics can encourage resilience, while ingredients that stimulate cell renewal help target concerns such as dullness, fine lines, and uneven tone. When first introduced, however, these powerful ingredients may bring underlying congestion to the surface, creating the temporary appearance of breakouts.
Purging vs Breakouts: How to Tell the Difference
Knowing whether you’re experiencing purging or a standard breakout helps you decide how to move forward:
Timing: Purging usually begins soon after introducing a new active ingredient.
Location: It tends to occur in areas already prone to congestion.
Duration: Most purging resolves within one skin cycle, usually four to six weeks.
If breakouts appear in new areas, persist longer than eight weeks, or cause significant discomfort, it may not be purging. In those cases, adjusting your routine or seeking professional advice is recommended.
How to Support Your Skin During Purging
Go slow: Introduce one new product at a time and allow your skin to adjust.
Keep it simple: Avoid layering too many strong actives in the same routine.
Stay hydrated: Use a nourishing moisturiser to comfort the skin.
Protect daily: Always apply SPF, as renewed skin can be more sun-sensitive.
Be gentle: Skip harsh scrubs or aggressive exfoliation, which can prolong irritation.
The Nu Allumé Approach
Our microbiome-focused menopause skincare is designed to work with your skin’s changing biology. Postbiotic ferments, gentle fruit acids, and proven actives like bakuchiol may trigger short-term purging for some women, but this stage often signals that renewal is underway. With consistent use, our customers find their skin feels smoother, more comfortable, and better supported through the changes of menopause.
Final Word
Skin purging can feel discouraging, but it is often a temporary adjustment. By understanding the difference between purging and breakouts, supporting your skin through the transition, and choosing microbiome-focused menopause skincare, you can give your skin the best chance to thrive.
Lactobacillus Ferment Filtrate: The Quiet Power Behind Resilient Skin
In skincare, some ingredients work only on the surface, offering quick fixes, while others go deeper, supporting the very ecosystem that keeps skin healthy. Lactobacillus Ferment Filtrate belongs firmly in the latter group. Rooted in the science of fermentation, this ingredient is now reshaping how we understand skin resilience, particularly during menopause.
What Is Lactobacillus Ferment Filtrate?
Lactobacillus Ferment Filtrate is created by fermenting Lactobacillus bacteria, long recognised for their role in gut and skin health. During fermentation, these microbes release a variety of beneficial compounds that the skin can readily absorb, thanks to their smaller, more bioavailable size. These include:
Amino acids and peptides: Support repair, hydration, and overall skin resilience.
Organic acids (such as lactic acid): Help maintain a healthy skin pH, gently exfoliate, and improve hydration.
Enzymes: Contribute to skin renewal and barrier recovery.
Antioxidants: Provide protection from oxidative stress and environmental damage.
Together, these compounds enhance the ingredient’s potency, allowing it to deliver benefits that extend far beyond basic hydration.
Why It Matters for Skin Health
The skin is constantly exposed to stress, whether from pollution, UV light, or internal changes such as menopause. Lactobacillus Ferment Filtrate helps meet these challenges by strengthening the barrier, calming irritation, and supporting a stable microbiome. Its humectant properties improve hydration, while its antioxidant activity offers protection against environmental aggressors. The result is skin that feels calmer, more resilient, and better equipped to adapt through change.
The Menopause–Microbiome Connection
Falling oestrogen during menopause doesn’t just affect collagen, it also alters the skin’s microbiome. This shift often leads to dryness, redness, breakouts, and slower recovery. By supporting the microbiome, Lactobacillus Ferment Filtrate helps skin adapt during this transition, providing comfort, hydration, and protection.
The Science Behind the Calm
Research has shown that topical application of Lactobacillus Ferment Filtrate can reduce signs of sensitivity such as stinging and itching, while boosting hydration. Its protective effects against pollution and oxidative stress make it a quiet yet powerful ally for long-term skin health.
How We Use It at Nu Allumé
Every formulation in the Nu Allumé range has a clear scientific purpose. We use Lactobacillus Ferment Filtrate to restore barrier strength, ease irritation linked to microbiome changes, and keep menopausal skin calm, hydrated, and resilient. Paired with Centella Asiatica, antioxidant complexes, and other ferments, it becomes part of a holistic approach to supporting the biology of skin in menopause.
Conclusion
Lactobacillus Ferment Filtrate may work in the background, but its impact is profound. By linking the science of fermentation to the needs of menopausal skin, it delivers resilience, hydration, and calm when skin needs it most — making it a cornerstone of Nu Allumé’s microbiome-focused skincare.
What Every Woman Should Know About Bone & Skin Health After 50
Turning 50 often marks a powerful life chapter, but it also brings big changes for our bones and skin. Both rely heavily on oestrogen, which drops sharply through perimenopause into menopause. Here is what is happening, why it matters, and exactly what you can do to stay strong, supple and radiant.
Why Bones Become More FragileAfter menopause, women can lose up to 20% of bone density within five years. This dramatically increases the risk of osteoporosis. Oestrogen helps regulate bone remodelling, the balance between breakdown and rebuilding. When oestrogen levels fall, bone breakdown outpaces formation, weakening the skeleton. Gut bacteria influence calcium absorption, immune signalling and oestrogen recycling, all of which are critical for bone strength.
Why Skin Loses Collagen and HydrationOestrogen drives collagen production and helps skin retain moisture. Research shows skin collagen content drops by as much as 30% in the first five years after menopause, leading to dryness, sagging and deeper lines even in skin that is not chronologically “old”. Gut imbalance fuels low‑grade inflammation that further degrades collagen and weakens the skin barrier.
Actionable Strategies for Strong Bones and Glowing Skin
Nourish from Within
Calcium and vitamin D: aim for 1,200 mg calcium and 800–1,000 IU vitamin D each day.
Protein and collagen: target 1 to 1.2 g protein per kg bodyweight and consider marine collagen supplements.
Fibre and fermented foods: feed beneficial gut bacteria with oats, onions, bananas and live yoghurt or kefir.
Move Your BodyWeight‑bearing exercise such as walking or dance boosts bone densityStrength training two to three times per week preserves muscle, bone and collagen
Gentle Skin CareChoose gentle cleansers and moisturisers with prebiotic ingredients like Nu Allumé Rosella Radiance Serum and postbiotic support from Nu Allumé Aloe and Snow Peach Day Moisturiser to calm inflammation and strengthen your barrier.
Healthy Habits
Get seven to eight hours of sleep each night and practise relaxation to lower stress hormones
Limit alcohol and sugar, both of which disrupt gut balance and increase inflammation
When to Talk to Your DoctorConsider a bone density scan if you are over 50 or have risk factors such as a family history of osteoporosis or low body weight. Discuss hormone replacement therapy if menopausal symptoms significantly affect your quality of life, as it can help preserve bone density and support skin health.
Your Next Chapter Starts NowAge is inevitable, but accelerated bone loss and skin ageing do not have to be. By focusing on gut health, nutrient‑rich foods, targeted exercise and microbiome‑friendly skincare, you can keep bones strong, skin resilient and embrace this vibrant stage of life with confidence.